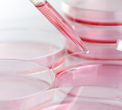

Retirenet Media Team

From radioligand therapies like Pluvicto to emerging immunotherapies and oral hormone blockers, explore the most promising innovations reshaping advanced prostate cancer care for men over 55.
Read more...
Dr. Matthew Edlund, MD, MOH

People are living longer than they did a hundred years ago. One major reason: far more effective control of infectious disease. But modern times have also seen a rise in cancer—one in six of which is caused by infection.
Read more...
Editorial Staff

Research shows that ethnic minorities are more likely to develop cancer and die from it, but are historically underrepresented in clinical trials. As part of lung cancer awareness month, a frequent speaker on health issues provides his take.
Read more...
Letha Hadady

Found in: Alternative Health
Overweight, stress, and pollution: We have heard of these risk factors for cancers. But others may be in your kitchen. Sugar, caffeine, and aflotoxins are among the prime culprits that can increase the likelihood of serious disease.
Read more...
Letha Hadady

Found in: Alternative Health, Diet & Nutrition
The sun lifts our spirits and enhances digestion, circulation, and well-being. And there's another reason to bask in the sun: most Americans suffer from an unrecognized deficiency of vitamin D, which we get from sunshine.
Read more...
Retirenet Media Team

Found in: Exercise & Fitness
Did you know regular exercise can help lower your risk of colon cancer? Staying active supports digestion, reduces inflammation, and promotes overall health. Learn how fitness can protect you and find easy ways to incorporate movement into your daily rout
Read more...
Retirenet Media Team

Women are disproportionately underrepresented in cancer research, affecting diagnosis, treatment, and outcomes. Explore the impact of this gap and why it's crucial to push for more inclusive studies that prioritize women's health in cancer research.
Read more...
Editorial Staff

Over the next 20 years, the number of new cancer cases diagnosed annually in the United States will increase by 45 percent, from 1.6 million in 2010 to 2.3 million in 2030.
Read more...